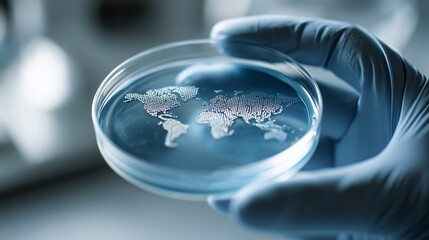
Hand in blue glove holds petri dish with world map illustration over blue fluid background. Concept for global research, disease control and pharmaceutical development

- Home >
- Stock Photos >
- World Map Highlighting Global Coronavirus Spread with Red Zones
World Map Highlighting Global Coronavirus Spread with Red Zones Image

This digitally generated map showcases the prevalent spread of COVID-19 across the globe, with red zones indicating high impact areas. Ideal for illustrating discussions or articles focused on global health, epidemiology, or the socio-economic effects of the pandemic. Useful in educational materials to convey the scope of international outbreak response and virus tracking efforts. Enhances presentations that target public health awareness and emergency preparedness.
downloads
Tags:
More
Credit Photo
If you would like to credit the Photo, here are some ways you can do so
Text Link
photo Link
<span class="text-link">
<span>
<a target="_blank" href=https://pikwizard.com/photo/world-map-highlighting-global-coronavirus-spread-with-red-zones/e666c83319ea8705012da090da7e14a9/>PikWizard</a>
</span>
</span>
<span class="image-link">
<span
style="margin: 0 0 20px 0; display: inline-block; vertical-align: middle; width: 100%;"
>
<a
target="_blank"
href="https://pikwizard.com/photo/world-map-highlighting-global-coronavirus-spread-with-red-zones/e666c83319ea8705012da090da7e14a9/"
style="text-decoration: none; font-size: 10px; margin: 0;"
>
<img src="https://pikwizard.com/pw/medium/e666c83319ea8705012da090da7e14a9.jpg" style="margin: 0; width: 100%;" alt="" />
<p style="font-size: 12px; margin: 0;">PikWizard</p>
</a>
</span>
</span>
Free (free of charge)
Free for personal and commercial use.
Author: Awesome Content
Similar Free Stock Images
Loading...